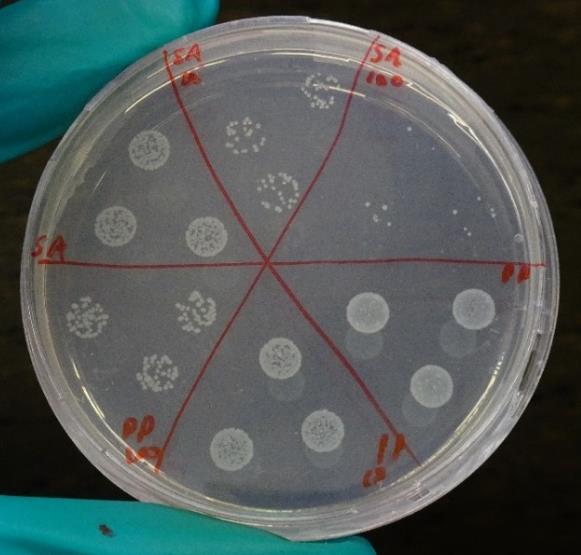

Kunststoffe sind aus unserem Alltag nicht mehr wegzudenken – sie ermöglichen Fortschritt in nahezu allen technischen Bereichen. Als moderne Polymerwerkstoffe leisten sie einen zentralen Beitrag zu innovativen Produkten und nachhaltigen Lösungen.
Warum lohnt sich diese Vertiefung?
Kunststoffe prägen unseren Alltag – von der Lebensmittelverpackung bis zum Hightech-Bauteil im Flugzeugbau. Sie ermöglichen leichte, stabile und funktionale Lösungen in zahlreichen Industrien wie Luftfahrt, Medizintechnik oder Automobilbau. Mit der Vertiefung Kunststofftechnik spezialisieren Sie sich auf einen Werkstoffbereich, der Innovation vorantreibt – wirtschaftlich, nachhaltig und technisch vielseitig.
Wie lernst du in dieser Vertiefung?
Du arbeitest mit modernen Polymerwerkstoffen und lernst deren Eigenschaften, Einsatzgebiete und Verarbeitungstechniken kennen. In enger Zusammenarbeit mit dem Institut für Kunststofftechnik FHNW und dem Institut für Nanotechnische Kunststoffanwendungen FHNW verbindest du Theorie mit praktischer Anwendung in Forschung, Labor und Projektarbeit. Tradition und Know-how aus über 50 Jahren fliessen direkt in Ihre Ausbildung ein.
Was erwartet dich konkret?
Du beschäftigst dich mit:
- verstärkten und unverstärkten Polymerwerkstoffen
- deren Berechnung, Gestaltung und Fertigung
- modernen Spritzgiessverfahren und der Verarbeitung von Composites
- Recyclingkonzepten und Nachhaltigkeit im Werkstoffdesign
Von Nanostrukturen bis zu faserverstärkten Leichtbauteilen – du gestaltest die Kunststofftechnik von morgen mit. Diese Vertiefung eröffnet dir vielfältige Berufsperspektiven in der Industrie, z. B. in der Produktentwicklung, Prozessoptimierung oder Anwendungstechnik.
Studierendenprojekte in Kunststofftechnik
Antimikrobielle Ausrüstung von Polypropylen für Anwendungen im Kompostbereich

Entwicklung und Umsetzung eines Kriechprüfstands zur Charakterisierung des Langzeitverhaltens von faserverstärkten Bauteilen


